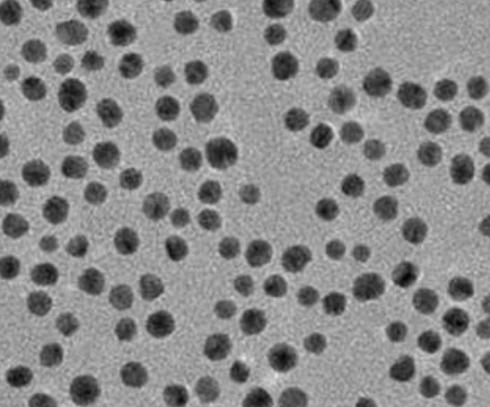
image.png

Carboxyl-PEG Linker Gold Nanoparticles 羧基PEG连接金纳米粒子
英文音标名:Carboxyl-PEG Linker Gold Nanoparticles 简体中文:羧基PEG对接金納米物体讲述:金納米球车辆系列车辆通过圆形金納米科粒生产的加工技艺光催化原理而成,长宽透亮,小粒直径区域范畴瓣膜反流,分散型性好,无凝心聚力。金納米球小粒直径从20 nm减少至100 nm其外层等正离子体共震挥发峰从520 nm红移至570 nm,挥发峰也是比较窄的,小粒直径100 nm之上的金納米科粒,则具备宽光谱图挥发。技术性产品参数:粒度分布範圍:10-400 nm均一度电:CV%<12%存在的高度的稳固性,可均分离而无沉降缓冲器液:DI water/0.01M PBS (pH 7.4)永久保存文档经济条件:阴凉, 4°C 保存文档,请勿冰冻

pg电子娱乐游戏app
微信公众号
官方微信